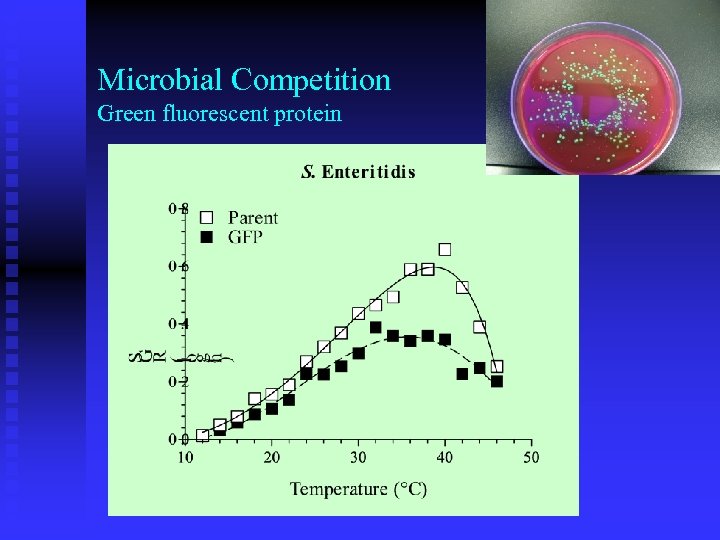
Microbial Competition Green fluorescent protein

3619bba01b41fb7d4215c5b4c8fd6f06.ppt
- Количество слайдов: 46
 Detection and Enumeration of Food Pathogens with the BAX® PCR System Thomas P. Oscar, Ph. D. Research Food Technologist Welcome… …thank you for coming!
Detection and Enumeration of Food Pathogens with the BAX® PCR System Thomas P. Oscar, Ph. D. Research Food Technologist Welcome… …thank you for coming!
 Detection and Enumeration of Food Pathogens with the BAX® PCR System Thomas P. Oscar, Ph. D. Research Food Technologist Welcome… …thank you for coming!
Detection and Enumeration of Food Pathogens with the BAX® PCR System Thomas P. Oscar, Ph. D. Research Food Technologist Welcome… …thank you for coming!
 University of Delaware (1978 -1982) n Undergraduate Research Assistant u B. S. in Animal Science t Pre-Veterinary Medicine “Interaction of Tiamulin and Monensin in Chickens”
University of Delaware (1978 -1982) n Undergraduate Research Assistant u B. S. in Animal Science t Pre-Veterinary Medicine “Interaction of Tiamulin and Monensin in Chickens”
 Pennsylvania State University (1982 -1984) n Graduate Research Assistant u M. S. in Animal Nutrition t Minor in Biochemistry “Characterization of the Bovine Mammary Insulin Receptor”
Pennsylvania State University (1982 -1984) n Graduate Research Assistant u M. S. in Animal Nutrition t Minor in Biochemistry “Characterization of the Bovine Mammary Insulin Receptor”
 North Carolina State University (1984 -1987) n Graduate Research & Teaching Assistant u Ph. D. in Animal Science t Ruminant Nutrition “Role of Nickel in Methane Production”
North Carolina State University (1984 -1987) n Graduate Research & Teaching Assistant u Ph. D. in Animal Science t Ruminant Nutrition “Role of Nickel in Methane Production”
 University of Tennessee, Memphis (1987 -1988) n NIH Post-Doctoral Research Associate u Type II Diabetes t Rat Fat Cell Model
University of Tennessee, Memphis (1987 -1988) n NIH Post-Doctoral Research Associate u Type II Diabetes t Rat Fat Cell Model
 West Virginia University (1988 -1992) n Assistant Professor of Animal Science u Growth & Development u Meat Technology “Hormonal Regulation of Lipolysis in Chicken Fat Cells”
West Virginia University (1988 -1992) n Assistant Professor of Animal Science u Growth & Development u Meat Technology “Hormonal Regulation of Lipolysis in Chicken Fat Cells”
 ARS, Poultry Research Laboratory Georgetown, DE (1992 -1994) n Research Physiologist (Poultry) u Growth & Development UMES Delmarva Poultry Industry “Improve the Lean-to-Fat Ratio of Broiler Chickens”
ARS, Poultry Research Laboratory Georgetown, DE (1992 -1994) n Research Physiologist (Poultry) u Growth & Development UMES Delmarva Poultry Industry “Improve the Lean-to-Fat Ratio of Broiler Chickens”
 ARS, Nutrient Conservation & Metabolism Lab Beltsville, MD (1994 -1995) n Research Dairy Scientist u Ruminant Nutrition Beltsville Agricultural Research Center
ARS, Nutrient Conservation & Metabolism Lab Beltsville, MD (1994 -1995) n Research Dairy Scientist u Ruminant Nutrition Beltsville Agricultural Research Center
 ARS, Microbial Food Safety Research Unit UMES, Princess Anne, MD (1995 -present) n Research Food Technologist u Predictive Microbiology u Outreach
ARS, Microbial Food Safety Research Unit UMES, Princess Anne, MD (1995 -present) n Research Food Technologist u Predictive Microbiology u Outreach
 Feature Presentation
Feature Presentation
 Current Food Safety Approach Jack-in-the-Box n n HACCP u No testing Performance Standards u Detection u Enumeration t C. jejuni To test or not to test, that is the question
Current Food Safety Approach Jack-in-the-Box n n HACCP u No testing Performance Standards u Detection u Enumeration t C. jejuni To test or not to test, that is the question
 Traditional Culture Method Detection and Enumeration n Pre-enrichment n Selective plating n Confirmation 5 to 7 Days
Traditional Culture Method Detection and Enumeration n Pre-enrichment n Selective plating n Confirmation 5 to 7 Days
 Rapid Detection Method BAX® PCR system 24 to 30 h 100 101 102 103 104 105 106 107 Bailey, J. S. 1998. J. Food Prot. 61: 792 -795.
Rapid Detection Method BAX® PCR system 24 to 30 h 100 101 102 103 104 105 106 107 Bailey, J. S. 1998. J. Food Prot. 61: 792 -795.
 Sample Incubation Important Factors • Food Factors • Inhibitors • Competition • Pathogen Factors • Injury • Strain • PCR Sensitivity PCR Detection Time Target pathogen (< 1/ml) • 104 cells/ml
Sample Incubation Important Factors • Food Factors • Inhibitors • Competition • Pathogen Factors • Injury • Strain • PCR Sensitivity PCR Detection Time Target pathogen (< 1/ml) • 104 cells/ml
 Sample Size Chicken carcass rinse n Salmonella Incidence u u 4. 9% for 10 ml 20. 5% for 270 ml Surkiewicz et al. , 1969. Food Tech. 23: 80 -85.
Sample Size Chicken carcass rinse n Salmonella Incidence u u 4. 9% for 10 ml 20. 5% for 270 ml Surkiewicz et al. , 1969. Food Tech. 23: 80 -85.
 Monte Carlo Simulation Extrapolation to other sample sizes 100, 10 g Samples Pathogen Incidence = 10/100 or 10%
Monte Carlo Simulation Extrapolation to other sample sizes 100, 10 g Samples Pathogen Incidence = 10/100 or 10%
 Monte Carlo Simulation Extrapolation to other sample sizes 10, 100 g Samples Pathogen Incidence = 6/10 or 60%
Monte Carlo Simulation Extrapolation to other sample sizes 10, 100 g Samples Pathogen Incidence = 6/10 or 60%
 Objectives n To develop a standard curve for enumerating food pathogens as a function of PCR detection time. n To determine the effects of strain variation, meat type and microbial competition on the shape of the standard curve. n To develop a Monte Carlo simulation model for enumeration of food pathogens as a function of sample size.
Objectives n To develop a standard curve for enumerating food pathogens as a function of PCR detection time. n To determine the effects of strain variation, meat type and microbial competition on the shape of the standard curve. n To develop a Monte Carlo simulation model for enumeration of food pathogens as a function of sample size.
 Materials and Methods n Salmonella u u n Typhimurium 14028 Worthington Starter cultures u 37°C for 23 h at 150 opm u Brain heart infusion broth
Materials and Methods n Salmonella u u n Typhimurium 14028 Worthington Starter cultures u 37°C for 23 h at 150 opm u Brain heart infusion broth
 Inoculated Pack Study Pre-enrichment Samples n Sample u n Inoculum u n 100. 7 to 106 CFU Incubation u n 25 g of chicken + 225 ml of buffered peptone water 37°C without shaking Sampling u 0, 2, 4, 6, 8, 10, 12, 24 h
Inoculated Pack Study Pre-enrichment Samples n Sample u n Inoculum u n 100. 7 to 106 CFU Incubation u n 25 g of chicken + 225 ml of buffered peptone water 37°C without shaking Sampling u 0, 2, 4, 6, 8, 10, 12, 24 h
 PCR Detection Time Score n PCR Analysis n Scoring System u BAX® System u 0 = no band u One gel per sample u 1 = faint band u 2 = < full band u 3 = full band
PCR Detection Time Score n PCR Analysis n Scoring System u BAX® System u 0 = no band u One gel per sample u 1 = faint band u 2 = < full band u 3 = full band
 Example Total Score 15 Subsample (h) 0 2 4 6 8 10 Score 0 0 1 2 3 3 12 24 MW 3 3
Example Total Score 15 Subsample (h) 0 2 4 6 8 10 Score 0 0 1 2 3 3 12 24 MW 3 3
 Dataset Sterile breast meat and Typhimurium 14028
Dataset Sterile breast meat and Typhimurium 14028
 Type of Chicken Meat Sterile cooked (autoclaved) chicken meat
Type of Chicken Meat Sterile cooked (autoclaved) chicken meat
 Previous Study Salmonella Typhimurium 14028 Oscar, 2002. Int. J. Food Microbiol. 76: 177 -190.
Previous Study Salmonella Typhimurium 14028 Oscar, 2002. Int. J. Food Microbiol. 76: 177 -190.
 Previous Study Salmonella Typhimurium 14028 Oscar, 2002. Int. J. Food Microbiol. 76: 177 -190.
Previous Study Salmonella Typhimurium 14028 Oscar, 2002. Int. J. Food Microbiol. 76: 177 -190.
 Conclusion n Dilution may minimize effects of the food matrix on PCR detection time score.
Conclusion n Dilution may minimize effects of the food matrix on PCR detection time score.
 Strain Variation 117 Salmonella Isolates Chicken Operations
Strain Variation 117 Salmonella Isolates Chicken Operations
 Previous Study Strain variation at 40°C in brain heart infusion broth Typhimurium Worthington Oscar, 1998. J. Food Prot. 61: 964 -968.
Previous Study Strain variation at 40°C in brain heart infusion broth Typhimurium Worthington Oscar, 1998. J. Food Prot. 61: 964 -968.
 Results Naturally contaminated breast skin
Results Naturally contaminated breast skin
 Generation Time n Variation among 45 strains of S. Enteritidis was: u u 22% at 9°C 4% at 37°C Fehlhaber and Kruger, 1998. J. Appl. Microbiol. 84: 945 -949.
Generation Time n Variation among 45 strains of S. Enteritidis was: u u 22% at 9°C 4% at 37°C Fehlhaber and Kruger, 1998. J. Appl. Microbiol. 84: 945 -949.
 Conclusion n Strain variation may not greatly affect PCR detection time score under optimal growth conditions.
Conclusion n Strain variation may not greatly affect PCR detection time score under optimal growth conditions.
 Microbial Competition
Microbial Competition
 Microbial Competition Salmonella Typhimurium DT 104
Microbial Competition Salmonella Typhimurium DT 104
Microbial Competition Green fluorescent protein
Microbial Competition Green fluorescent protein
 Conclusion n Microbial competition affected PCR detection time score and thus, needs to be incorporated into the standard curve.
Conclusion n Microbial competition affected PCR detection time score and thus, needs to be incorporated into the standard curve.
 Monte Carlo Simulation Modeling
Monte Carlo Simulation Modeling
 Final Standard Curve 95% Prediction Interval
Final Standard Curve 95% Prediction Interval
 Simulation Model Excel + @Risk
Simulation Model Excel + @Risk
 Naturally Contaminated Chicken Not inoculated with Salmonella
Naturally Contaminated Chicken Not inoculated with Salmonella
 Effect of Sample Size Simulation results
Effect of Sample Size Simulation results
 Conclusion n Linear extrapolation of detection and enumeration results is not appropriate.
Conclusion n Linear extrapolation of detection and enumeration results is not appropriate.
 Future Research Enumeration n Automated BAX® System u n Cycle threshold rather than band width score. Other Pathogens and Foods
Future Research Enumeration n Automated BAX® System u n Cycle threshold rather than band width score. Other Pathogens and Foods
 The End Thank you for your attention! I will be glad to answer your questions
The End Thank you for your attention! I will be glad to answer your questions
 The End Thank you for your attention! I will be glad to answer your questions
The End Thank you for your attention! I will be glad to answer your questions


